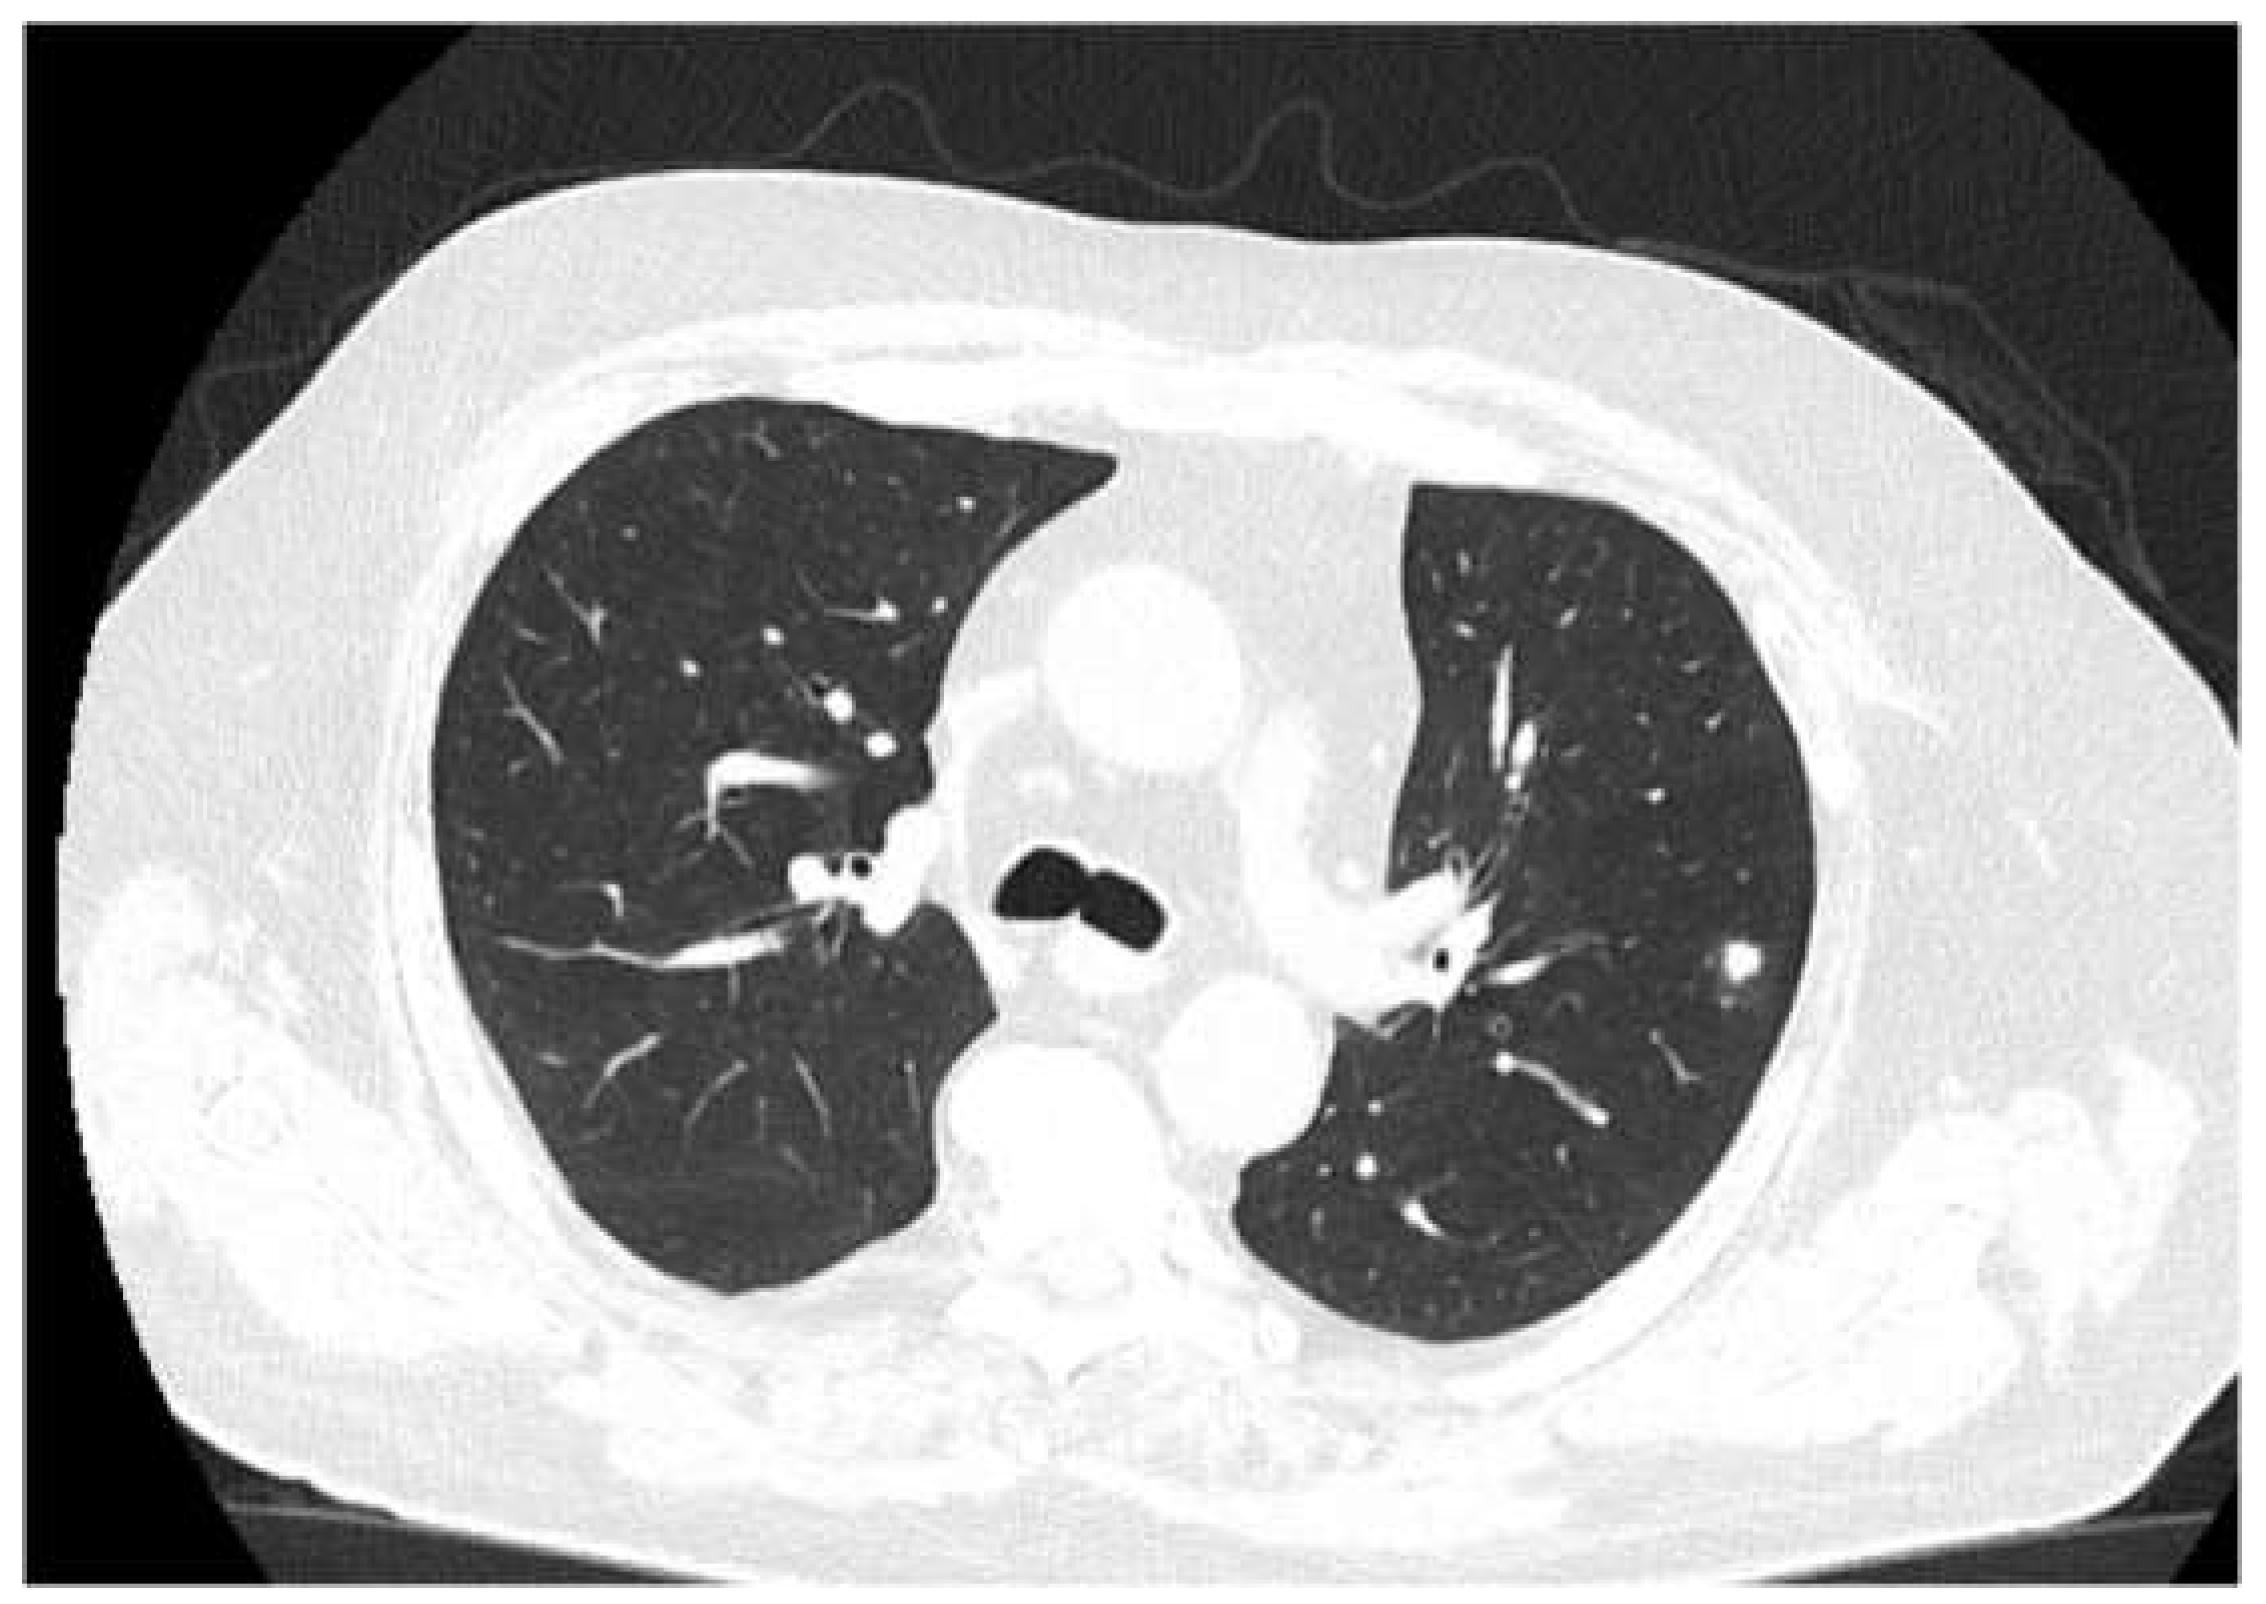

2. Case Report
A male patient, employed in the forestry industry, aged 58 and a nonsmoker, was diagnosed with chronic membranous glomerulonephritis and nephrotic syndrome in 2016. He was given 150mg of azathioprine (Imuran®) once a day (2mg/kg) for immunosuppressive therapy.
However, there was no improvement in proteinuria reduction, so after 4 weeks, methylprednisolone, an oral corticoid, was added to his treatment (64mg once a day). The steroid treatment helped to reduce proteinuria to about 500mg/l and it remained stable. The azathioprine treatment was stopped after 8 weeks because the patient developed an extensive area of herpes zoster covering 3 intercostal dermatomes.
The patient continued to receive chronic steroid treatment and had regular check-up visits in the nephrology department between 2016 and 2022. He was admitted several times for edema during this period and also developed hypertension and steroid-induced diabetes mellitus. To manage these conditions, he was prescribed ACE inhibitors, calcium channel blockers, high-potency statin, and insulin in a basal-bolus regimen. The proteinuria was dose-dependent and at lower doses than the 16 mg methylprednisolone threshold, the proteinuria was not controlled.
During this period the serum creatinine remained at a stable level of 1 mg/dL
In early May 2023, the patient developed a respiratory illness that was treated with iv. gentamycin and ceftriaxone for 7 days in a territorial hospital and discharged. In late May 2023 he developed right retrorbital pain, painful right red eye with acute vision loss, headaches, 7 kg weight loss, and aggravated fatigue that were not controlled with usual medication and cough. The patient was admitted to the Internal Medicine Department for further evaluation. We performed a native cranial CT (
Figure 1) and an MRI without contrast which showed multiple lesions -10- that were classified as undetermined lesions on CT scan and possible abscessed metastases on the MRI.
It was suspected that there was a metastatic tumor and a full-body CT scan was performed (
Figure 2). The CT scan discovered multiple abscesses in the lungs and under the skin. A second contrast MRI (
Figure 3) scan was conducted which revealed abscesses in all parts of the brain, including the right thalamus and left cerebellar hemisphere, with ring-like contrast-enhancing lesions. However, the lesions were relatively stable compared to the previous MRI.
The full-body CT scan showed multiple nodular cavitating lesions spread throughout the pulmonary area and several subcutaneous abscesses in various locations, with one notable abscess in the distal portion of the anterior serratus muscle and right pre-pectoral subcutaneous fat. Additionally, there were multiple nodules on the peritoneum and perisplenic fat, all measuring between 2-3 cm in diameter.
The initial bloodwork showed mild leucocytosis (15000/mm3), with normal procalcitonin and a CRP of 11.6 mg/L, an ESR of 49 mm/h, a 2.3g proteinuria, a creatinine of 1.2 mg/dL and otherwise unremarkable biochemistry. Blood cultures were sterile and a subcutaneous abscess was drained and sent to the laboratory for analysis (
Figure 4). The patient was started on empirical antibiotics with iv meropenem 500 mg t.i.d. and amoxicillin/clavulanate 1g b.i.d. The initial clinical course was favorable, with remission of head pain.
The antibiogram showed that the species was in fact rod-shaped with filamentous ramification gram-negative bacteria, which was identified as Nocardia farcinica which had a susceptibility to linezolid and was resistant to imipenem, amikacin, and intermediate to amoxicillin-clavulanate (
Figure 6). The patient was started on a combination of linezolid 600mg bid, and trimethoprim/sulfamethoxazole 400 mg/ 80 mg t.i.d. Also a meropenem resistance study was performed which showed resistance to meropenem, and thus it was stopped in day 6 and continued on the other two antimicrobials, but relapsed on the pain scale
The subsequent clinical course after meropenem was stopped was relatively severe, with the patient developing intense right eye pain and a sudden drop in visual acuity, that required a step-up of pain medication, eventually, the patient received a combination of metamizole, tramadol, acetaminophen, pethidine, and nefopam. Even so, the patient declared a 10/10 Borg RPE pain score. The second MRI showed right posterior eye pole thickening and retroorbital edema, highly suspicious of retinal detachment, which the ophtalmology consult confirmed as no light perception, so the decision was made to readminister meropenem, again with a decrease in the pain scale. Also there was a spike in CRP level corroborated with withdrawal of meropenem and improvement with its re-administration. After re-administration of meropenem, the clinical course dramatically improved, and the patient received only on-demand acetaminophen.
The patient received also a regimen aimed at reducing brain edema with dexamethasone, mannitol, and complex B vitamin, altogether reducing the proteinuria to 0.3 g/L.
The total duration of the three antibiotics combined was 35 days, and the patient was discharged with a diagnosis of disseminated Nocardia farcinica infection, recommending a continuation of trimethoprim/sulfamethoxazole for at least one year.
The patient received a follow-up brain MRI and chest CT (
Figure 5) at 3 months, which showed complete remission of the brain abscess.
Figure 1.
Initial cranial CT (no contrast).
Figure 1.
Initial cranial CT (no contrast).
Figure 2.
-CT (with contrast, showing disseminated lesions in lungs, abdomen, and soft tissues (the arrows indicate the evacuated abscess).
Figure 2.
-CT (with contrast, showing disseminated lesions in lungs, abdomen, and soft tissues (the arrows indicate the evacuated abscess).
Figure 3.
MRI (different sequences showing brain abscesses).
Figure 3.
MRI (different sequences showing brain abscesses).
Figure 4.
Macroscopic aspect of the evacuated subcutaneous abscess and microscopic aspect with ramified filamentous Gram-positive bacilli growing in an aerobic environment.
Figure 4.
Macroscopic aspect of the evacuated subcutaneous abscess and microscopic aspect with ramified filamentous Gram-positive bacilli growing in an aerobic environment.
Figure 5.
-Follow-up Ct at three months. The chest CT does not show any cavitating lesions, with residual scaring and healing processes of the lesions.
Figure 5.
-Follow-up Ct at three months. The chest CT does not show any cavitating lesions, with residual scaring and healing processes of the lesions.
Figure 6.
CRP level dynamics (the spike indicates meropenem withdrawal and corroborates with the sharp increase in headache intensity and retroorbital pain).
Figure 6.
CRP level dynamics (the spike indicates meropenem withdrawal and corroborates with the sharp increase in headache intensity and retroorbital pain).
Table 1.
Antibiogram for Nocardia farcinica (R-resistant, I-intermediate resistance, S-sensitive, Valoare-denotes minimal inhibitory concentration-MIC).
Table 1.
Antibiogram for Nocardia farcinica (R-resistant, I-intermediate resistance, S-sensitive, Valoare-denotes minimal inhibitory concentration-MIC).